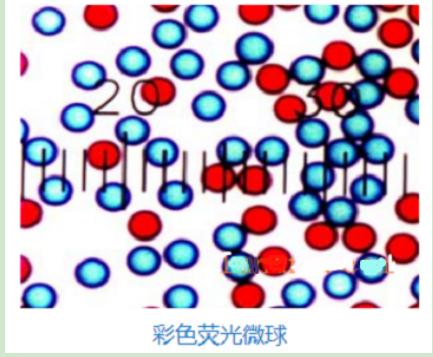
33.png 33.png

彩色乳胶微球 Color latex microsphere
Color latex microsphere
询价
2mg
起订
陕西 更新日期:2026-02-04
产品详情:
- 中文名称:
- 彩色乳胶微球
- 英文名称:
- Color latex microsphere
- 品牌:
- 西安齐岳
- 产地:
- 西安
- 保存条件:
- -20°C储存
- 纯度规格:
- 99%
- 产品类别:
- 微球
公司简介
西安齐岳生物科技有限公司是国内一家生物科技公司,我公司生产销售科研级别的药物传递和药物纳米靶向方面的产品,公司目前经营的产品主要有合成磷脂,PEG衍生物,嵌段共聚物,纳米金,磁性纳米颗粒,介孔二氧化硅,活性荧光染料,荧光量子点,点击化学和大环配体等等
| 成立日期 | (11年) |
| 注册资本 | 伍拾万元人民币 |
| 员工人数 | 10-50人 |
| 年营业额 | ¥ 100万以内 |
| 经营模式 | 试剂,定制,服务,试剂,定制,服务 |
| 主营行业 | 中间体,中间体,化学试剂,化学试剂 |
彩色乳胶微球相关厂家报价
-
- 氨基彩色微球
- 苏州为度生物技术有限公司
- 2026-04-05
- 询价
-
- 彩色微球 免疫层析
- 上海译元生物科技有限公司
- 2025-10-17
- ¥600
-
- 羧基修饰的蓝色聚苯乙烯彩色微球2um
- 陕西星贝爱科生物科技有限责任公司 VIP
- 2026-03-07
- 询价
-
- 彩色乳胶微球
- 河南威梯希化工科技有限公司 VIP
- 2026-03-03
- 询价